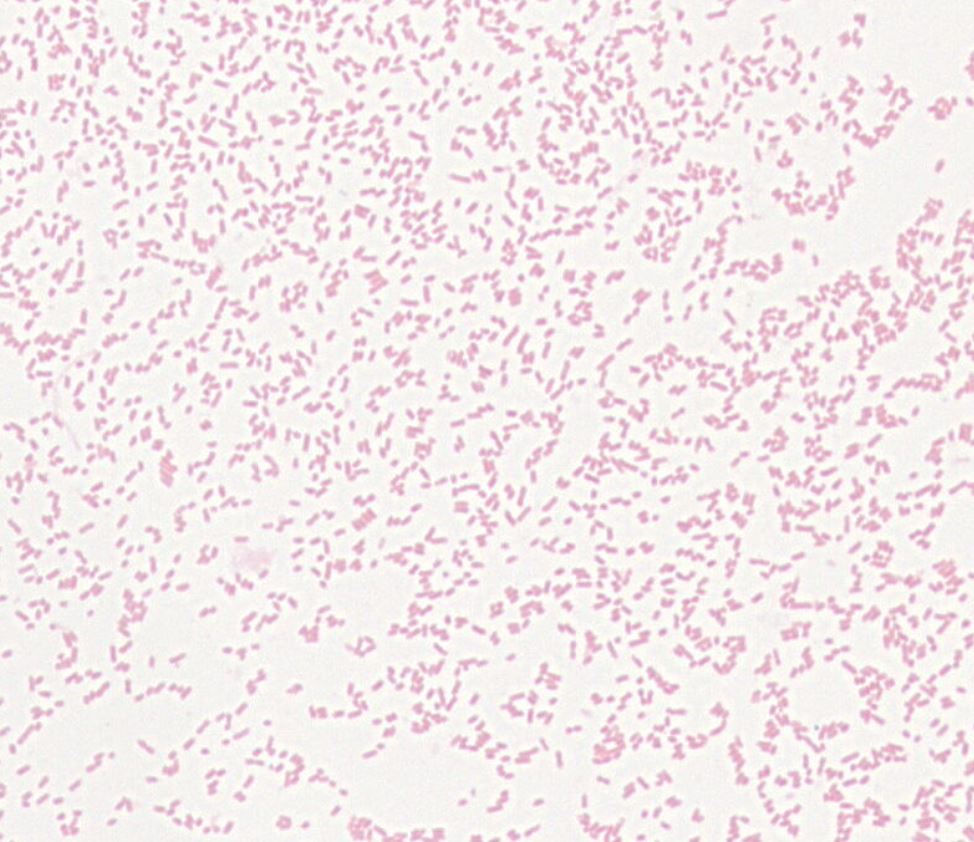
Edwardsiella sp. GMB1830

Edwardsiella sp. GMB1830
Product category: Bacteria
Product type: Facultative anaerobe
Species: Edwardsiella sp.
Strain Type: GMB1830
Staining Information: Gram negative
Growth Medium: JM medium
Culture Condition: 37℃
Product Format: Freeze dried ampoule
Storage Condition: 4~ -70 ℃
Characteristics: --
16s rRNA gene sequence: GGTGTGACGGGCGGTGTGTACAAGGCCCGGGAACGTATTCACCGTGGCATTCTGATCCACGATTACTAGCGATTCCGACTTCATGGAGTCGAGTTGCAGACTCCAATCCGGACTACGACGTACTTTATGAGGTCCGCTTGCTCTCGCGAGGTCGCTTCTCTTTGTATACGCCATTGTAGCACGTGTGTAGCCCTACTCGTAAGGGCCATGATGACTTGACGTCATCCCCACCTTCCTCCAGTTTATCACTGGCAGTCTCCTTTGAGTTCCCGGCCGAACCGCTGGCAACAAAGGATAAGGGTTGCGCTCGTTGCGGGACTTAACCCAACATTTCACAACACGAGCTGACGACAGCCATGCAGCACCTGTCTCAGCGTTCCCGAAGGCACTCCCGTATCTCTACAGGATTCGCTGGATGTCAAGAGTAGGTAAGGTTCTTCGCGTTGCATCGAATTAAACCACATGCTCCACCGCTTGTGCGGGCCCCCGTCAATTCATTTGAGTTTTAACCTTGCGGCCGTACTCCCCAGGCGGTCGATTTAACGCGTTAGCTTCGGAAGCCACGCCTCAAGGGCACAACCTCCAAATCGACATCGTTTACAGCGTGGACTACCAGGGTATCTAATCCTGTTTGCTCCCCACGCTTTCGCACCTGAGCGTCAGTCTTCGTCCAGGAGGCCGCCTTCGCCACCGGTATTCCTCCAGATCTCTACGCATTTCACCGCTACACCTGGAATTCTACCTCCCTCTACGAGACTCTAGCTTGCCAGTCTTGGATGCAGGTTCCCAGGTTAAGCCCGGGGATTTCACATCCAACTTAACAAACCGGCCTGCGT